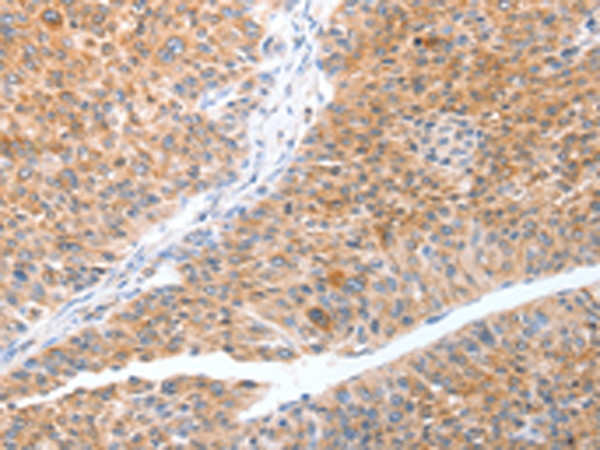
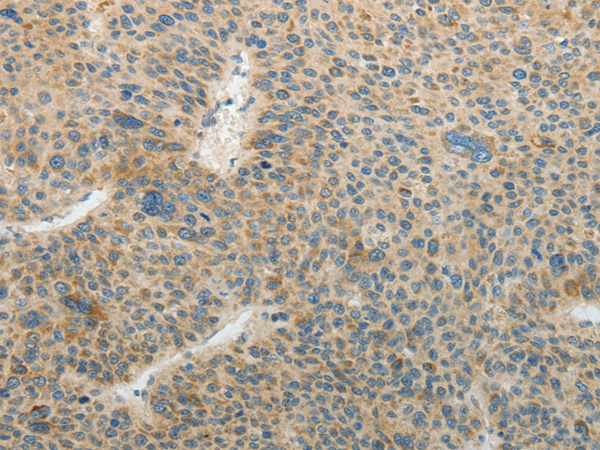

-
分类: 科研抗体货号: P07660别名:应用: WB,IHC反应种属: Human
-
分类: 科研抗体货号: P07676别名: T3JAM; DJ434O14.3应用: IHC反应种属: Human, Mouse
-
分类: 科研抗体货号: P07654别名: PP5; REF1; TFPI-2应用: WB,IHC反应种属: Human
-
分类: 科研抗体货号: P07659别名: TGE; UHS2应用: WB,IHC反应种属: Human
-
分类: 科研抗体货号: P07675别名: MIPT3; MIP-T3应用: WB,IHC反应种属: Human, Mouse, Rat
-
分类: 科研抗体货号: P07653别名: FX; FXA应用: WB反应种属: Human, Mouse, Rat
-
分类: 科研抗体货号: P07694别名:应用: IHC反应种属: Human, Mouse
-
分类: 科研抗体货号: P07674别名: EBI6; MGC:10353应用: WB,IHC反应种属: Human, Mouse
-
分类: 科研抗体货号: P07693别名: CT132; SPAS1; spergen1应用: IHC反应种属: Human
-
分类: 科研抗体货号: P07652别名: FIX; P19; PTC; HEMB; THPH8应用: WB反应种属: Human, Mouse, Rat

鄂公网安备42018502007531号
鄂公网安备42018502007531号

